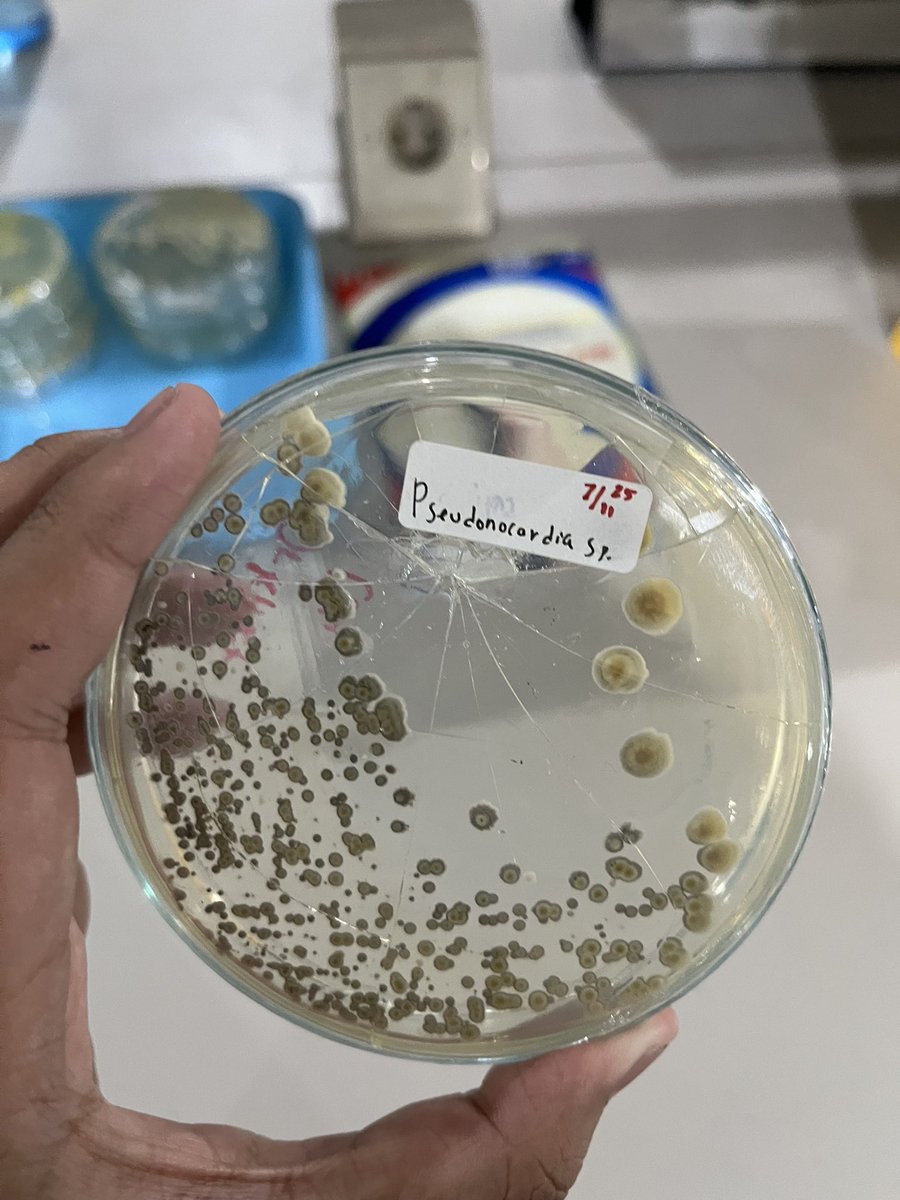
bumi tweet media

patir
3K posts


pernah ga lu shock isolatlu tbtb pecah sama lu udh bikin media banyak di cawan petri disposable terus ga nge set medianya… brengsek

bumi@bumikudonat
kok gapernah ada kisi kisi smt akhir sebajingan ini
Indonesia

adanya digebukin laprak doang mba
f@fiaaaahiew
adegan pulang kuliah dijemput kating sambil ditanyain "gimana tadi kuliahnya sayang?" itu smt brp sih?
Indonesia






